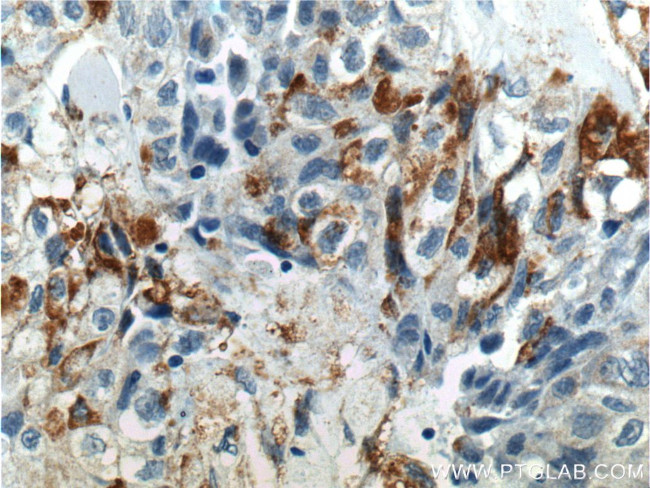
RSPO3 Antibody in Immunohistochemistry (Paraffin) (IHC (P))

Search
Proteintech
RSPO3 Polyclonal Antibody
{{$productOrderCtrl.translations['antibody.pdp.commerceCard.promotion.promotions']}}
{{$productOrderCtrl.translations['antibody.pdp.commerceCard.promotion.viewpromo']}}
{{$productOrderCtrl.translations['antibody.pdp.commerceCard.promotion.promocode']}}: {{promo.promoCode}} {{promo.promoTitle}} {{promo.promoDescription}}. {{$productOrderCtrl.translations['antibody.pdp.commerceCard.promotion.learnmore']}}
产品信息
17193-1-AP
种属反应
已发表种属
宿主/亚型
分类
类型
抗原
偶联物
形式
浓度
规格
纯化类型
保存液
内含物
保存条件
运输条件
产品详细信息
Immunogen sequence: GRRQRRMHP NVSQGCQGGC ATCSDYNGCL SCKPRLFFAL ERIGMKQIGV CLSSCPSGYY GTRYPDINKC TKCKADCDTC FNKNFCTKCK SGFYLHLGKC LDNCPEGLEA NNHTMECVSI VHCEVSEWNP WSPCTKKGKT CGFKRGTETR VREIIQHPSA KGNLCPPTNE TRKCTVQRKK CQKGERGKKG RERKRKKPNK GESKEAIPDS KSLESSKEIP EQRENKQQQK KRKVQDKQKS VSVSTVH (27-272 aa encoded by BC022367)
靶标信息
RSPO3 is a member of the R-spondin family and plays a role in the regulation of Wnt (wingless-type MMTV integration site family)/beta-catenin and Wnt/planar cell polarity (PCP) signaling pathways, which are involved in development, cell growth and disease pathogenesis. RSPO3 has been shown to be involved in regulating the balance between angioblast and blood cell specification during embryonic vasculogenesis and angiogenesis and may be involved in tumor development.
仅用于科研。不用于诊断过程。未经明确授权不得转售。
生物信息学
蛋白别名: Cabriolet; cristin 1; Cristin-1; Cysteine-rich and single thrombospondin domain-containing protein 1; hPWTSR; hRspo3; Nucleopondin; Protein with TSP type-1 repeat; R-spondin 3 homolog; R-spondin 3-like protein; R-spondin-3; Roof plate-specific spondin-3; Thrombospondin type-1 domain-containing protein 2; thrombospondin, type I, domain 2; thrombospondin, type I, domain containing 2; unnamed protein product
基因别名: 2810459H04Rik; AW742308; CRISTIN1; PWTSR; RGD1563246; RSPO3; THSD2
UniProt ID: (Human) Q9BXY4, (Mouse) Q2TJ95
Entrez Gene ID: (Human) 84870, (Mouse) 72780, (Rat) 498997